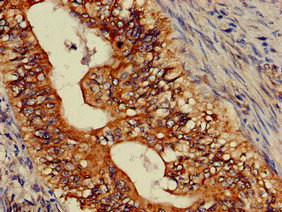

ASTN2 Antibody
-
中文名稱:ASTN2兔多克隆抗體
-
貨號:CSB-PA002252LA01HU
-
規格:¥440
-
圖片:
-
Western Blot
Positive WB detected in: PC-3 whole cell lysate
All lanes: ASTN2 antibody at 3.4µg/ml
Secondary
Goat polyclonal to rabbit IgG at 1/50000 dilution
Predicted band size: 149, 143, 148, 50, 45 kDa
Observed band size: 149 kDa -
Immunohistochemistry of paraffin-embedded human thyroid tissue using CSB-PA002252LA01HU at dilution of 1:100
-
Immunohistochemistry of paraffin-embedded human colon cancer using CSB-PA002252LA01HU at dilution of 1:100
-
Immunofluorescent analysis of HepG2 cells using CSB-PA002252LA01HU at dilution of 1:100 and Alexa Fluor 488-congugated AffiniPure Goat Anti-Rabbit IgG(H+L)
-
-
其他:
產品詳情
-
產品名稱:Rabbit anti-Homo sapiens (Human) ASTN2 Polyclonal antibody
-
Uniprot No.:
-
基因名:
-
別名:Astn2 antibody; ASTN2_HUMAN antibody; Astrotactin 2 antibody; Astrotactin-2 antibody; bA264C15.1 antibody; bA67K19.1 antibody; KIAA0634 antibody
-
宿主:Rabbit
-
反應種屬:Human
-
免疫原:Recombinant Human Astrotactin-2 protein (108-272AA)
-
免疫原種屬:Homo sapiens (Human)
-
標記方式:Non-conjugated
本頁面中的產品,ASTN2 Antibody (CSB-PA002252LA01HU),的標記方式是Non-conjugated。對于ASTN2 Antibody,我們還提供其他標記。見下表:
-
克隆類型:Polyclonal
-
抗體亞型:IgG
-
純化方式:>95%, Protein G purified
-
濃度:It differs from different batches. Please contact us to confirm it.
-
保存緩沖液:Preservative: 0.03% Proclin 300
Constituents: 50% Glycerol, 0.01M PBS, pH 7.4 -
產品提供形式:Liquid
-
應用范圍:ELISA, WB, IHC, IF
-
推薦稀釋比:
Application Recommended Dilution WB 1:500-1:5000 IHC 1:20-1:200 IF 1:50-1:200 -
Protocols:
-
儲存條件:Upon receipt, store at -20°C or -80°C. Avoid repeated freeze.
-
貨期:Basically, we can dispatch the products out in 1-3 working days after receiving your orders. Delivery time maybe differs from different purchasing way or location, please kindly consult your local distributors for specific delivery time.
-
用途:For Research Use Only. Not for use in diagnostic or therapeutic procedures.
相關產品
靶點詳情
-
功能:Mediates recycling of the neuronal cell adhesion molecule ASTN1 to the anterior pole of the cell membrane in migrating neurons. Promotes ASTN1 internalization and intracellular transport of endocytosed ASTN1. Selectively binds inositol-4,5-bisphosphate, inositol-3,4,5-trisphosphate and inositol-1,3,4,5-tetrakisphosphate, suggesting it is recruited to membranes that contain lipids with a phosphoinositide headgroup (Ref.6).
-
基因功能參考文獻:
- ASTN2 localizes primarily to endocytic and autophagocytic vesicles in the cell soma and in subsets of dendritic spines PMID: 30242134
- Our study suggests that the MEF2D, PRDM16 and ASTN2 genes from GWAS are associated with migraine susceptibility, especially migraine without aura , among Chinese patients. It appears that there is no association with serotonin receptor related genes. PMID: 28058730
- The findings of this study do not support a major role of ASTN2 variants in ADHD or its comorbid disorders respective aADHD associated personality traits. PMID: 27138430
- Results present the structure of ASTN-2 consisting of a combination of polypeptide folds: a perforin-like domain, a minimal epidermal growth factor-like module, a unique form of fibronectin type III domain and an annexin-like domain. Structural and biophysical data show that ASTN-2 binds inositol triphosphates, suggesting a mechanism for membrane recognition or secondary messenger regulation of its activity. PMID: 27249642
- The expression of coding and non-coding genes with SAFB1 cross-link sites was altered by SAFB1 knockdown. The isoform-specific expression of neural cell adhesion molecule (NCAM1) and ASTN2 was influenced by SAFB1. PMID: 26694817
- Study found a significant association of ASTN2 genetic variants with age at onset in Alzheimer's disease in two independent samples together with in silico analysis that demonstrated potential role of ASTN2 in the pathogenesis of the disease PMID: 25410587
- rs4836732 may contribute to hip OA susceptibility by altering proximal femur shape. PMID: 25939412
- 3' terminal ASTN2 deletions are significantly enriched in males with neurodevelopmental disorders, but not in females. PMID: 24381304
- Single nucleotide polymorphism in ASTN2 gene is associated with cognition disorders. PMID: 22504421
- Clinical trial and genome-wide association study of gene-disease association. (HuGE Navigator) PMID: 20195266
顯示更多
收起更多
-
亞細胞定位:Membrane; Multi-pass membrane protein. Perikaryon. Cytoplasm, cell cortex. Early endosome. Late endosome. Cytoplasmic vesicle, clathrin-coated vesicle. Cytoplasmic vesicle.
-
蛋白家族:Astrotactin family
-
數據庫鏈接:
Most popular with customers
-
-
YWHAB Recombinant Monoclonal Antibody
Applications: ELISA, WB, IHC, IF, FC
Species Reactivity: Human, Mouse, Rat
-
Phospho-YAP1 (S127) Recombinant Monoclonal Antibody
Applications: ELISA, WB, IHC
Species Reactivity: Human
-
-
-
-
-